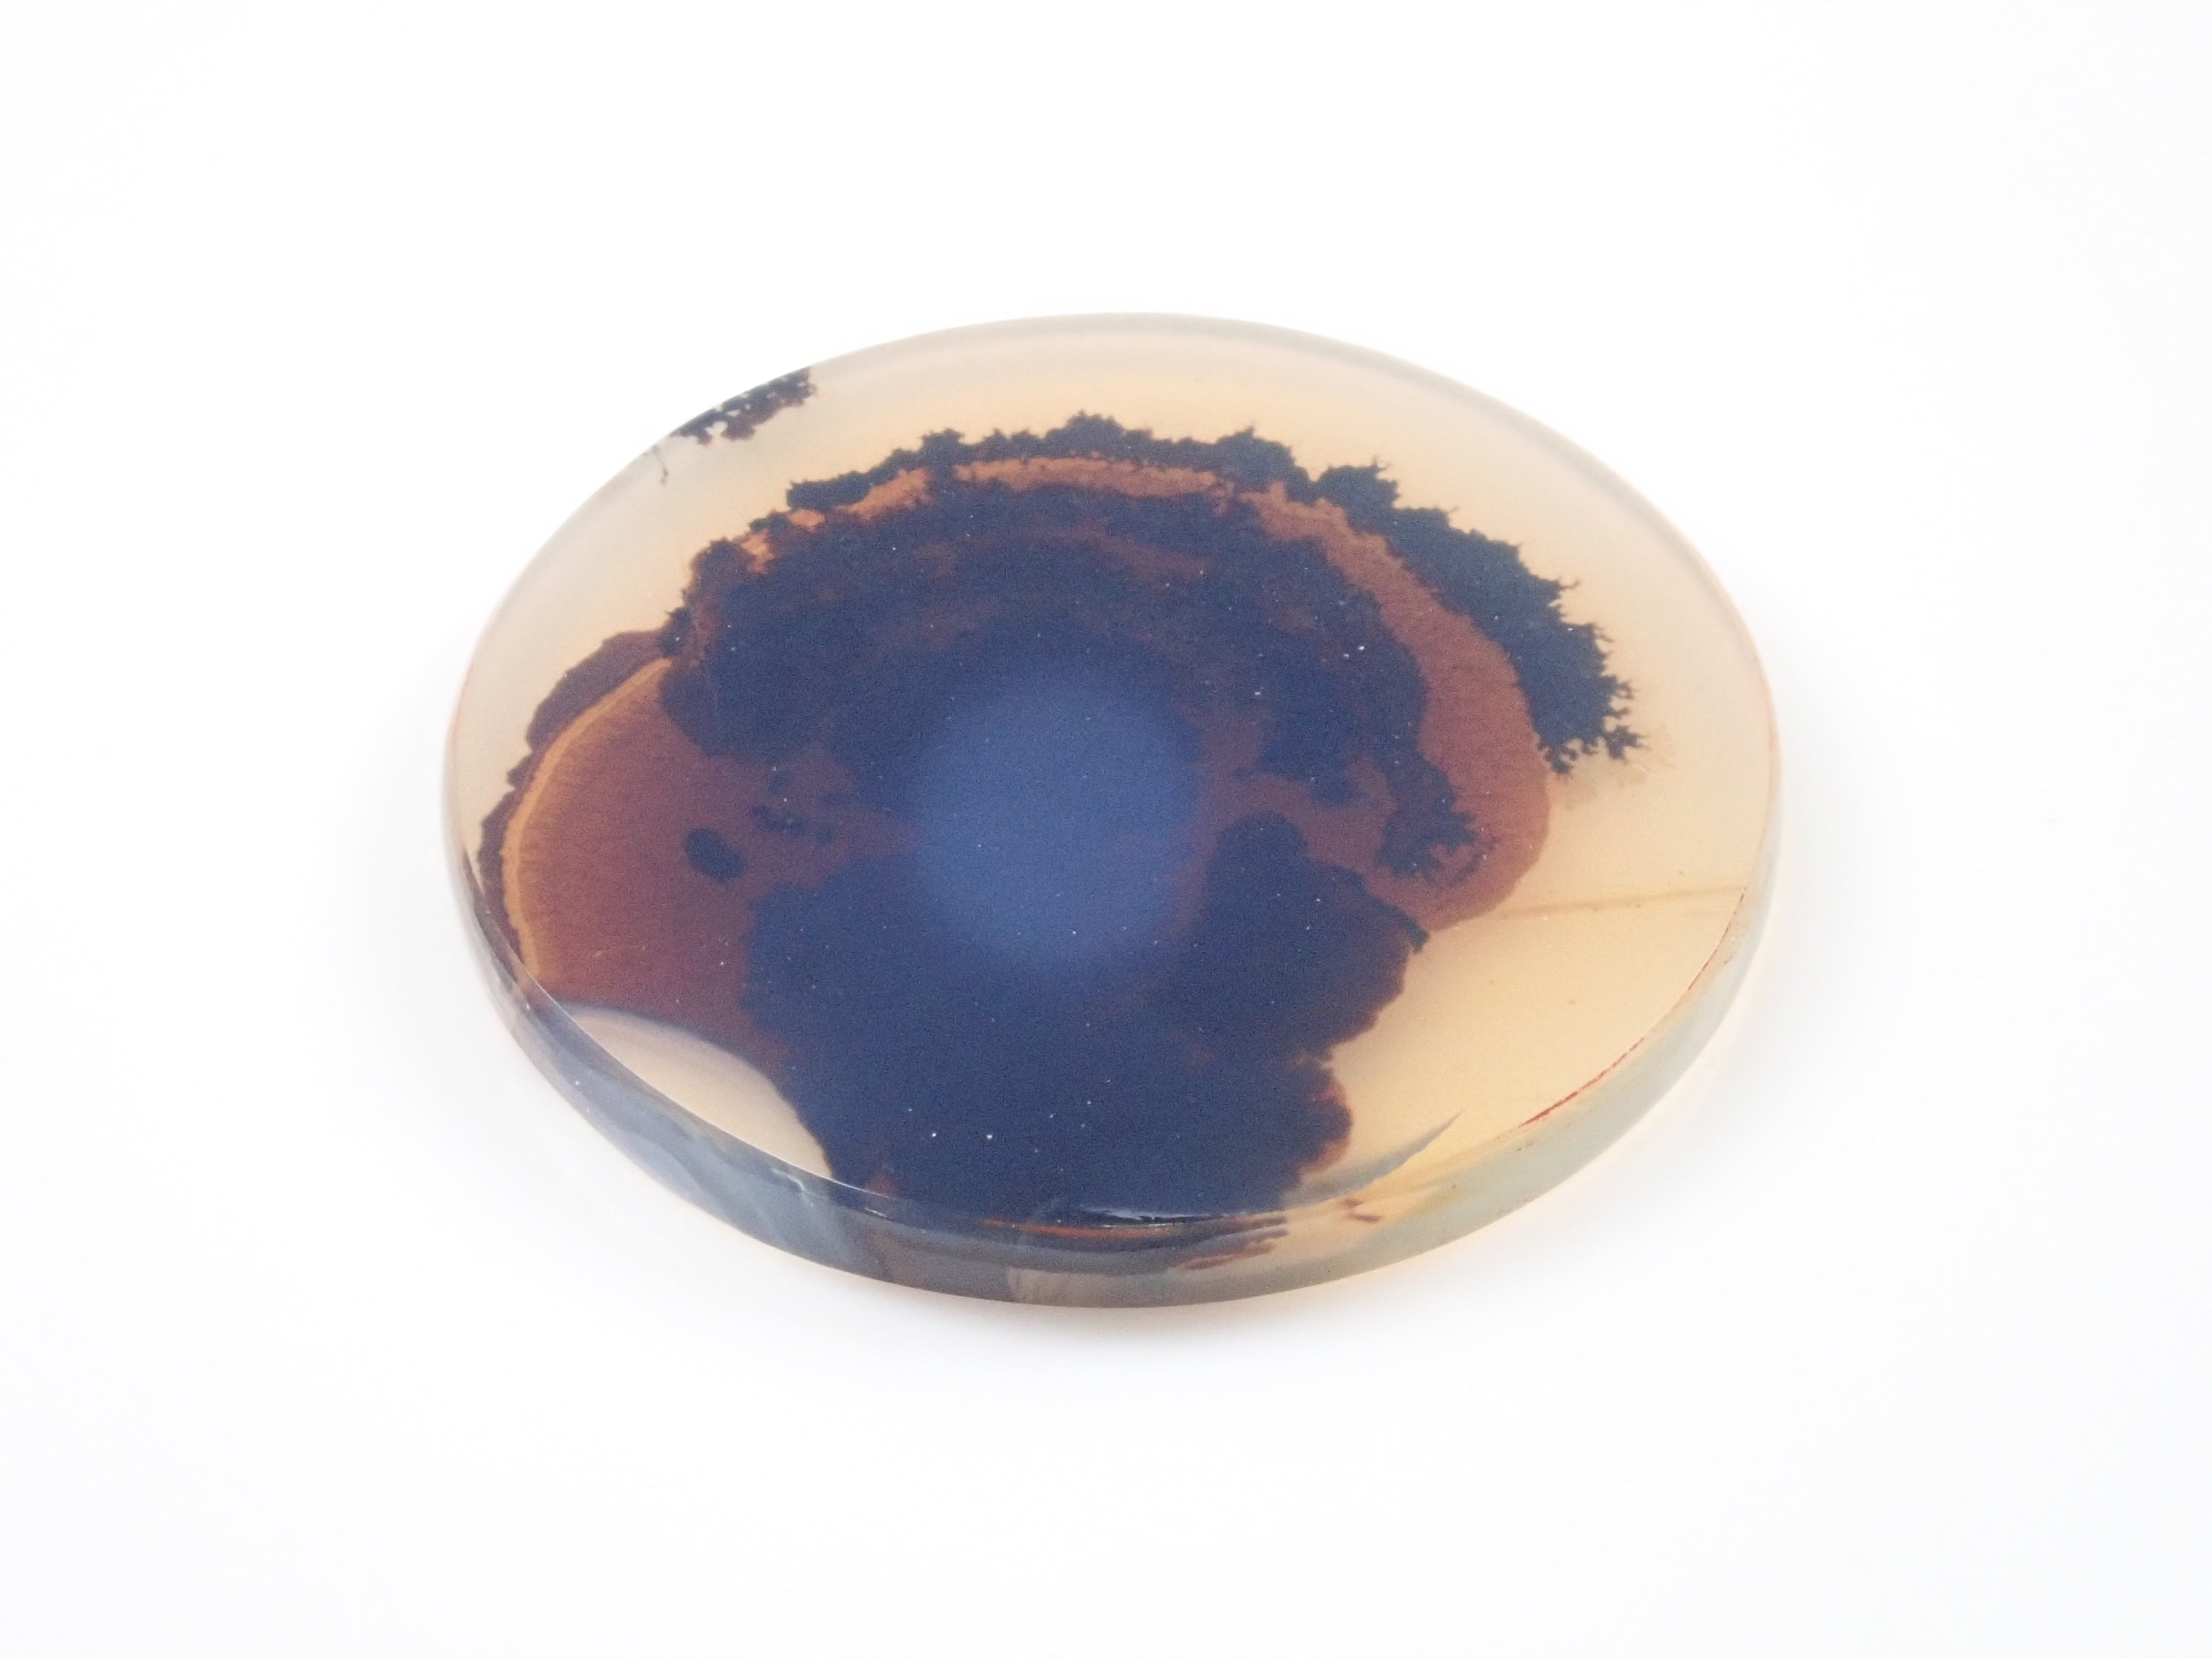
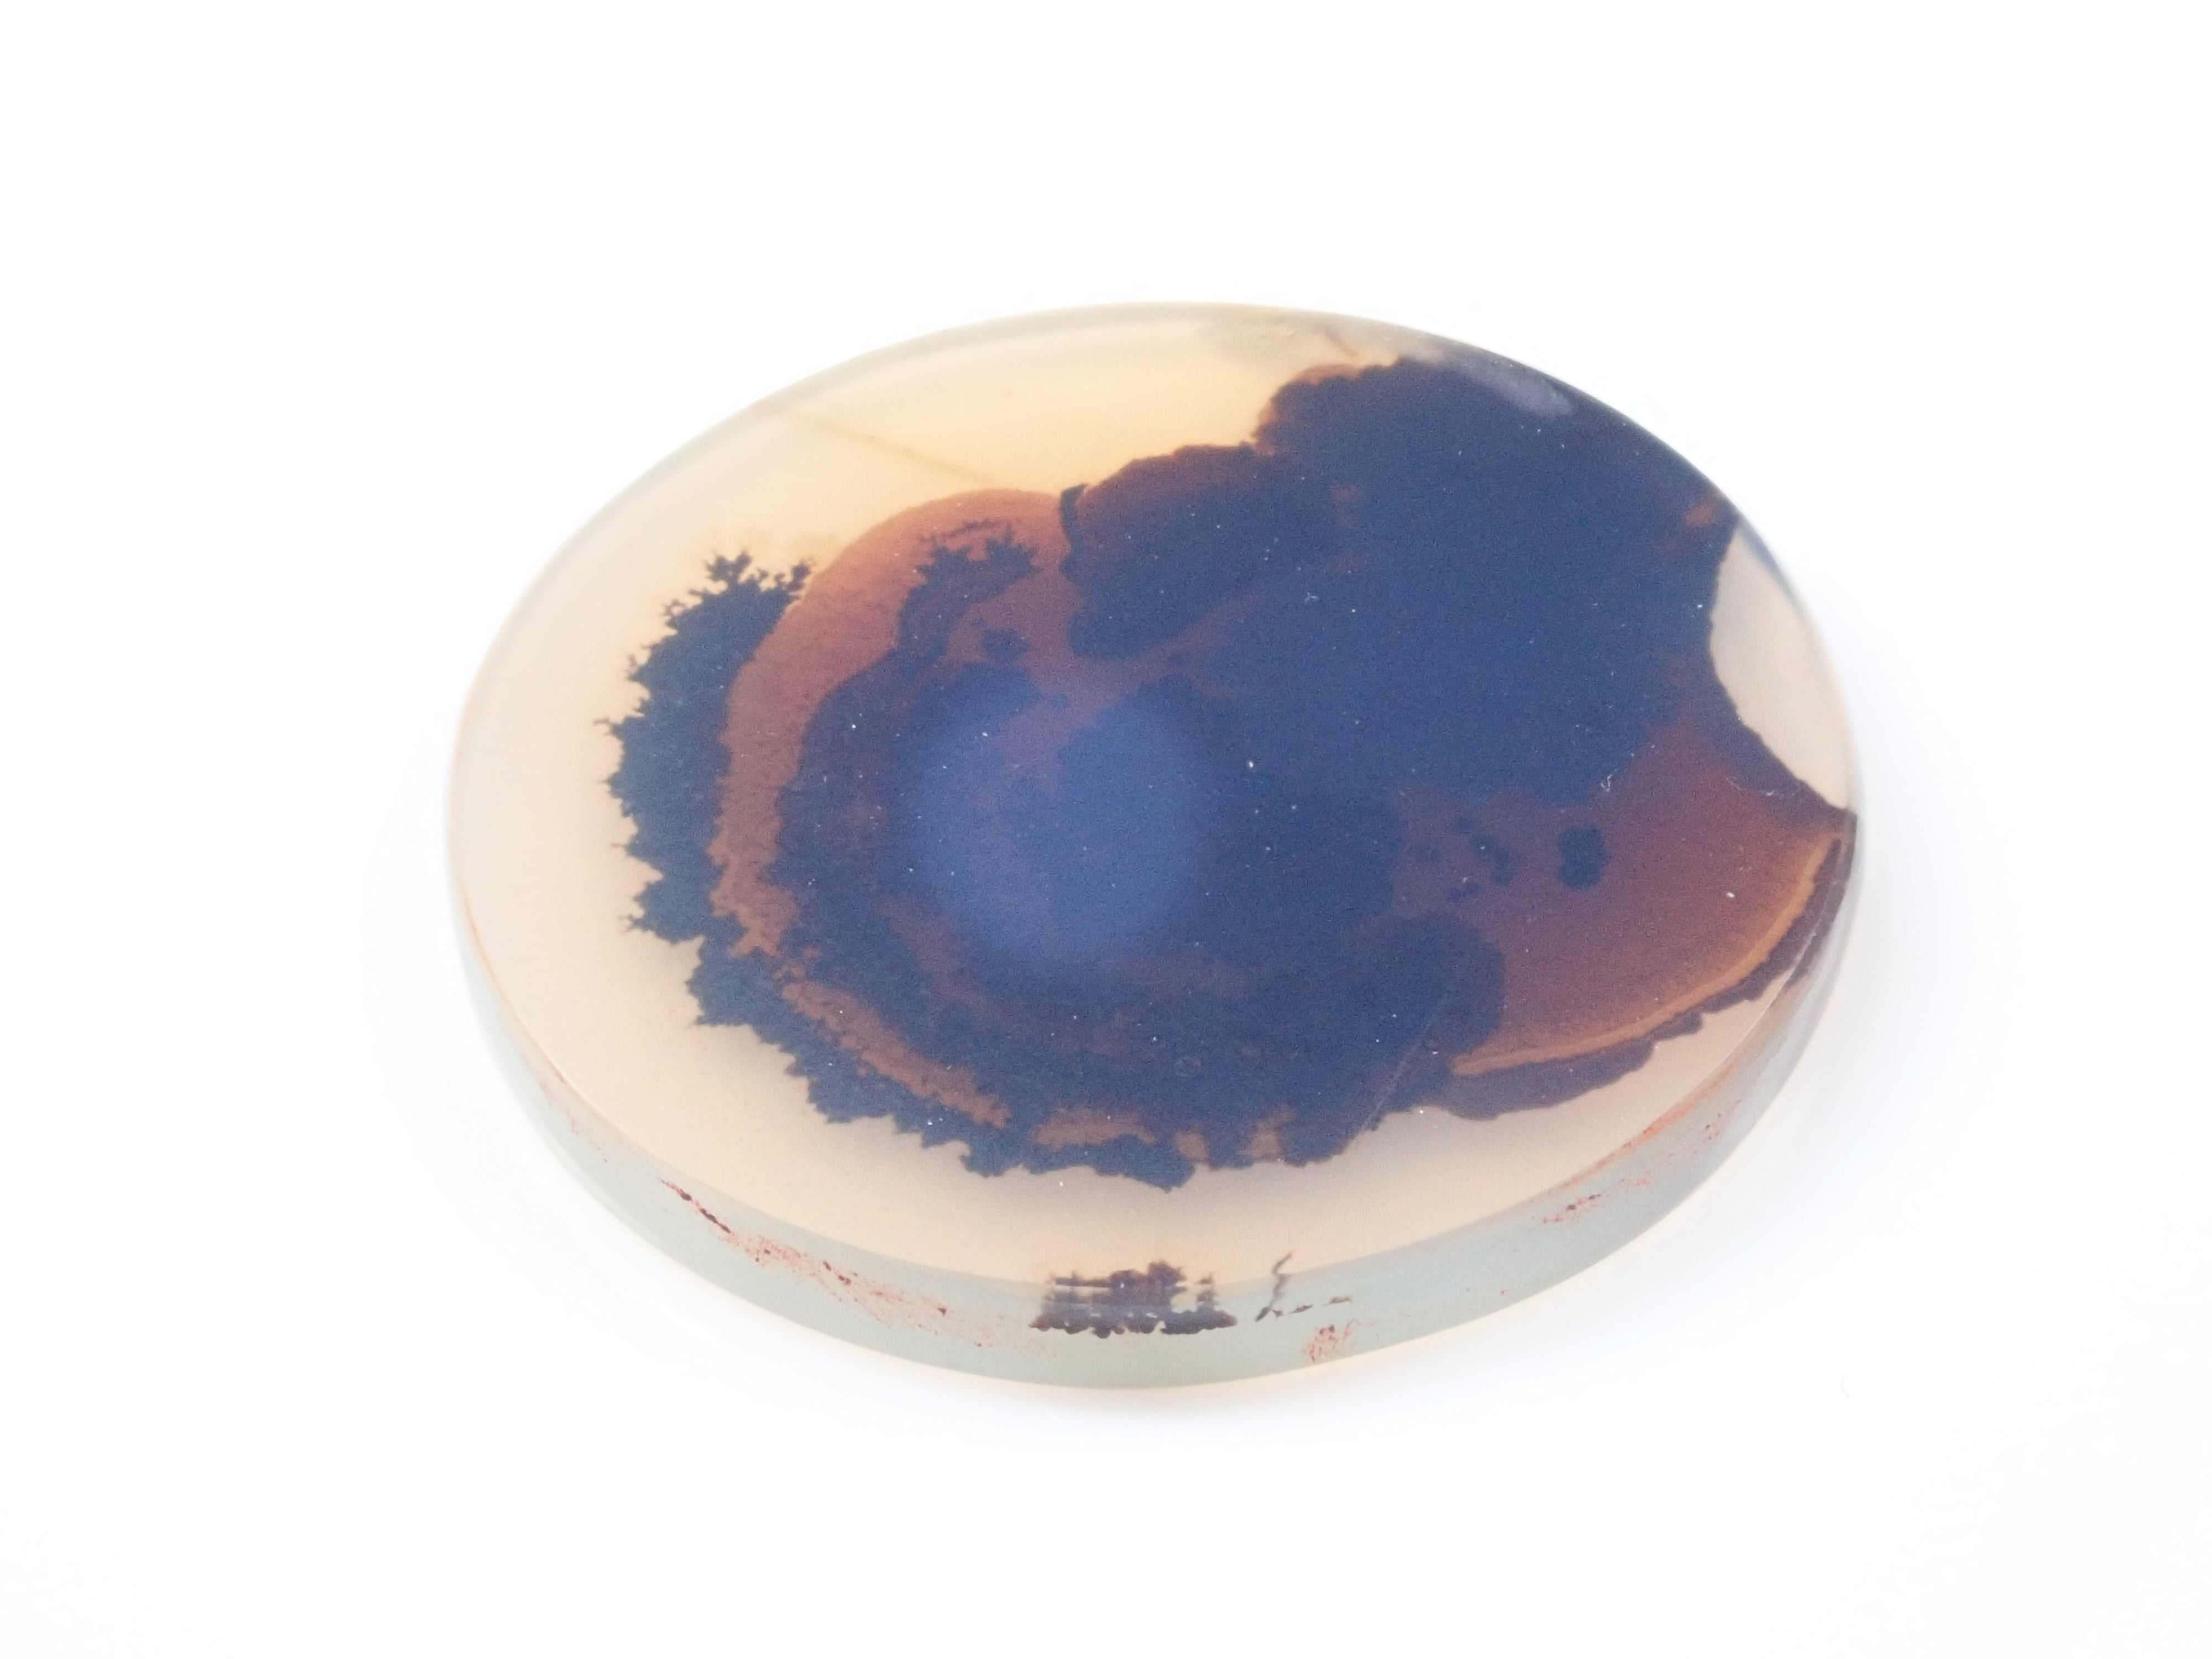
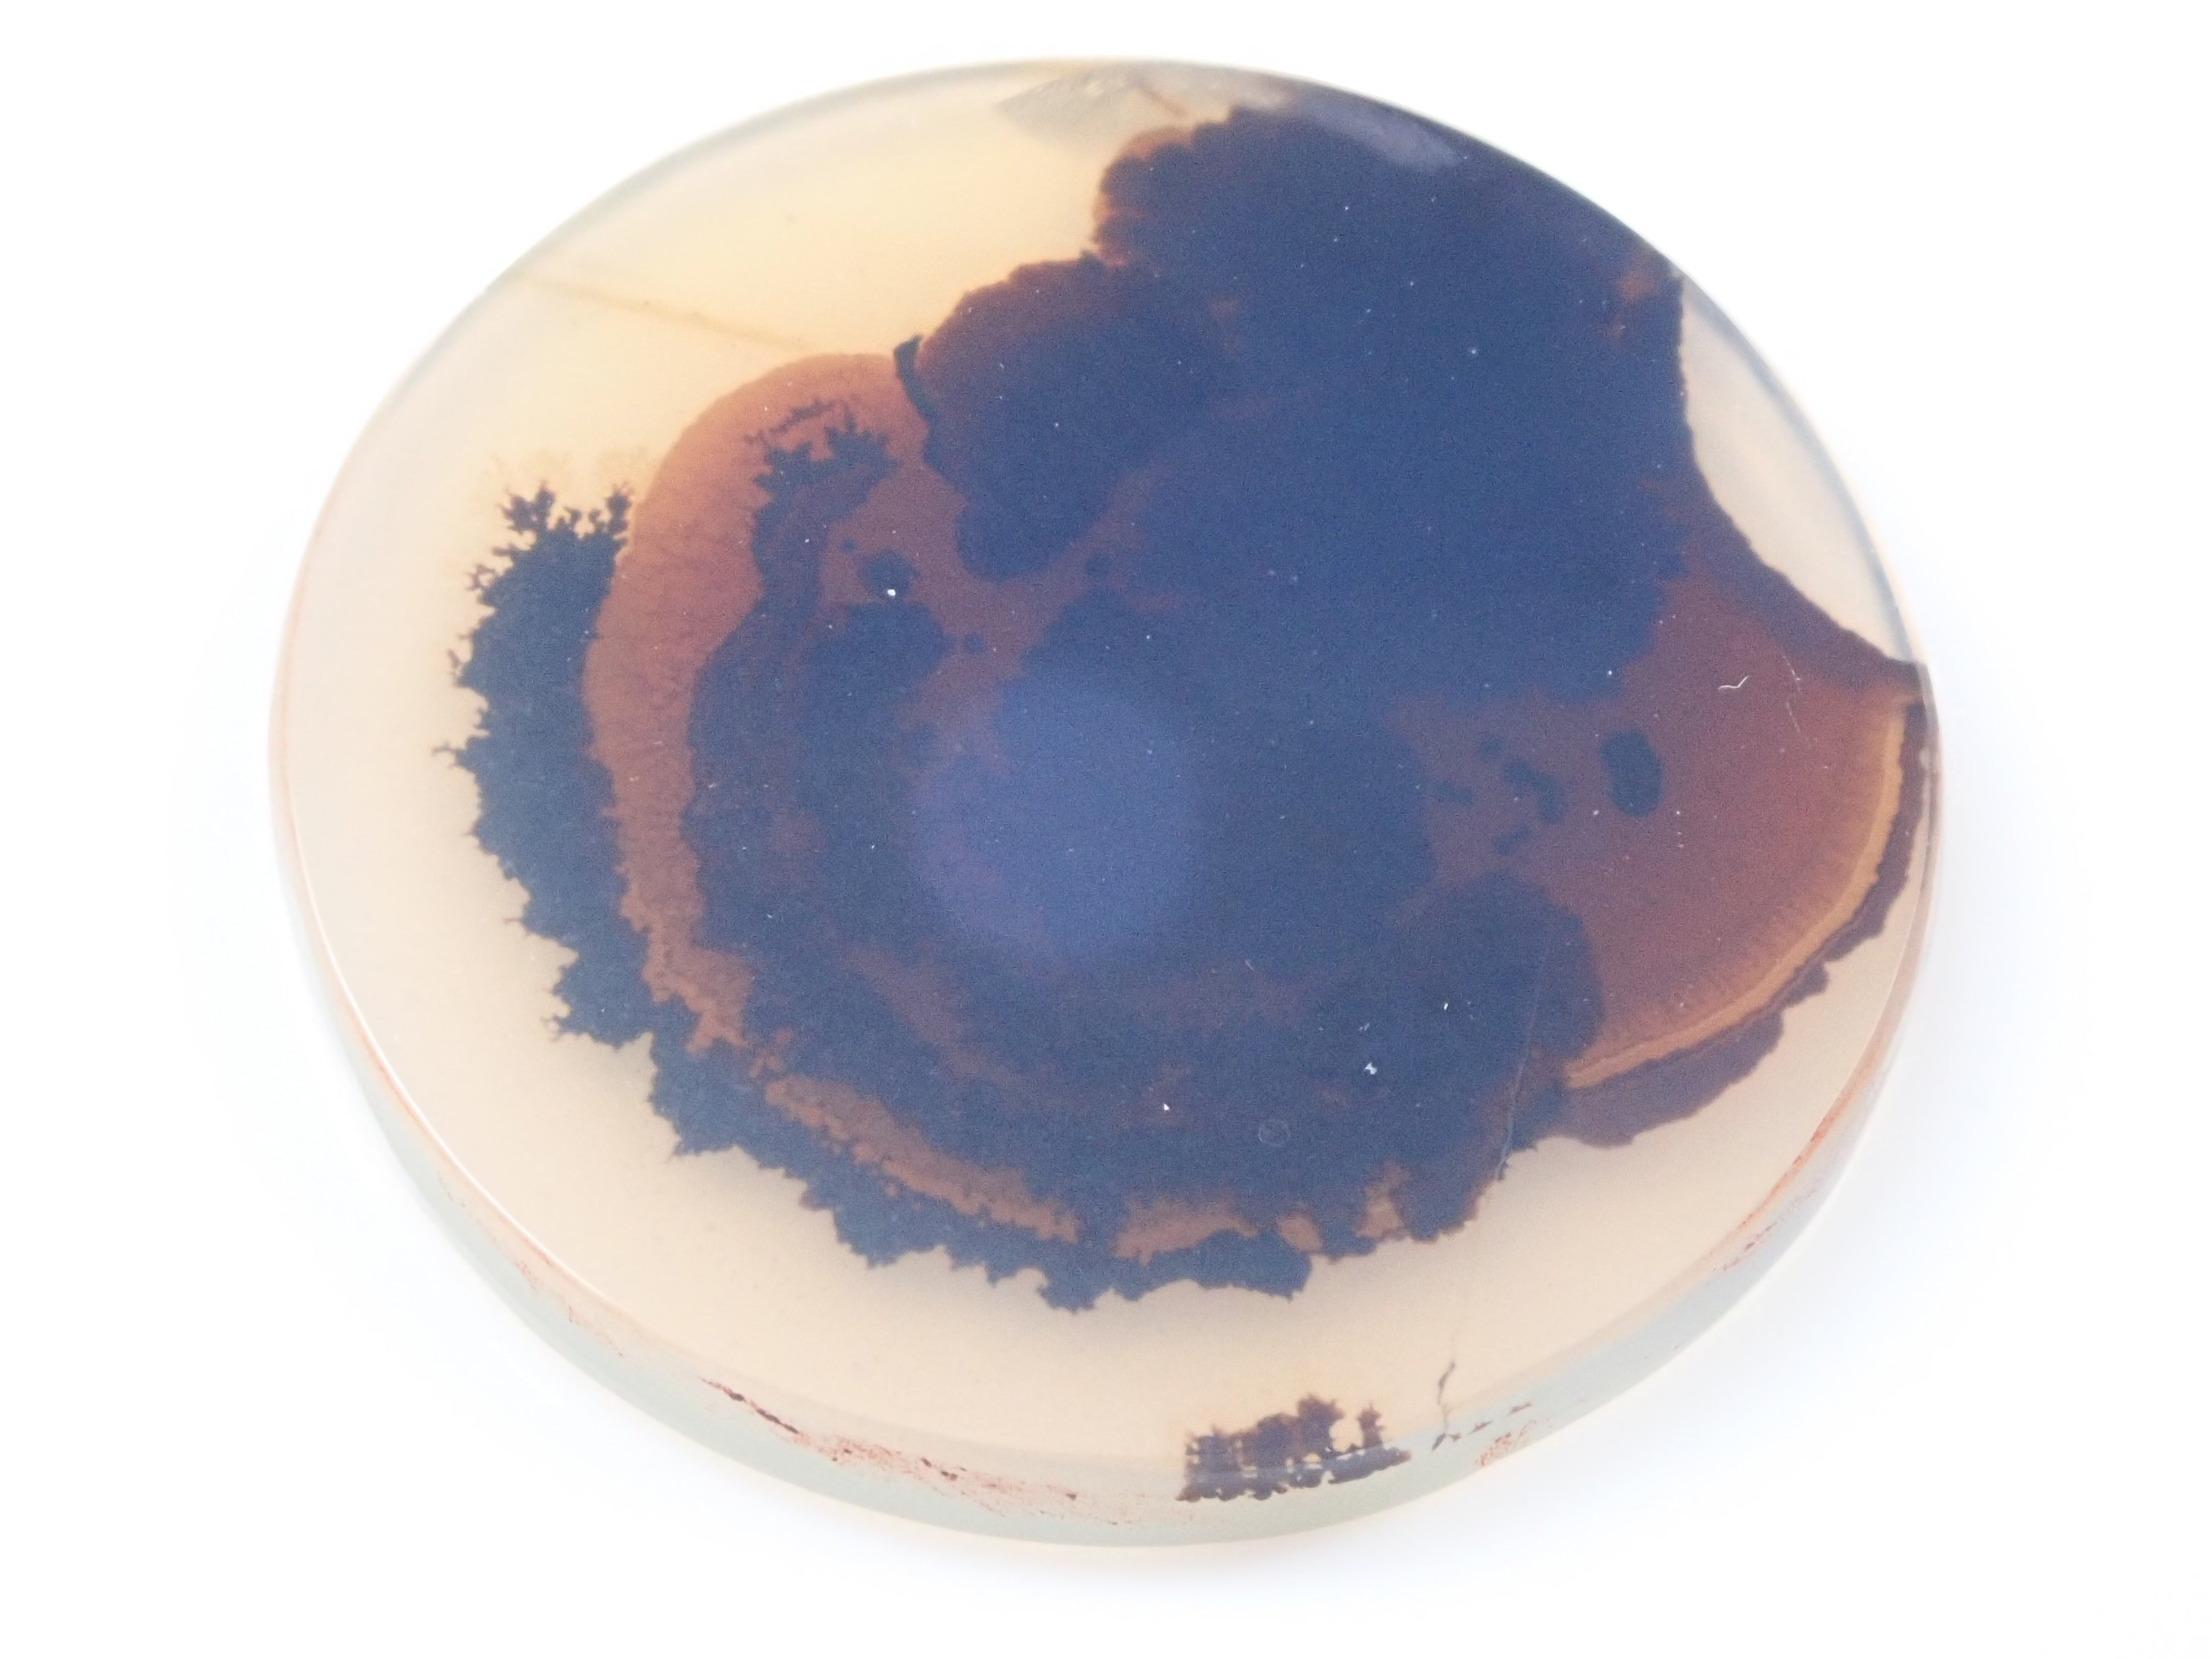
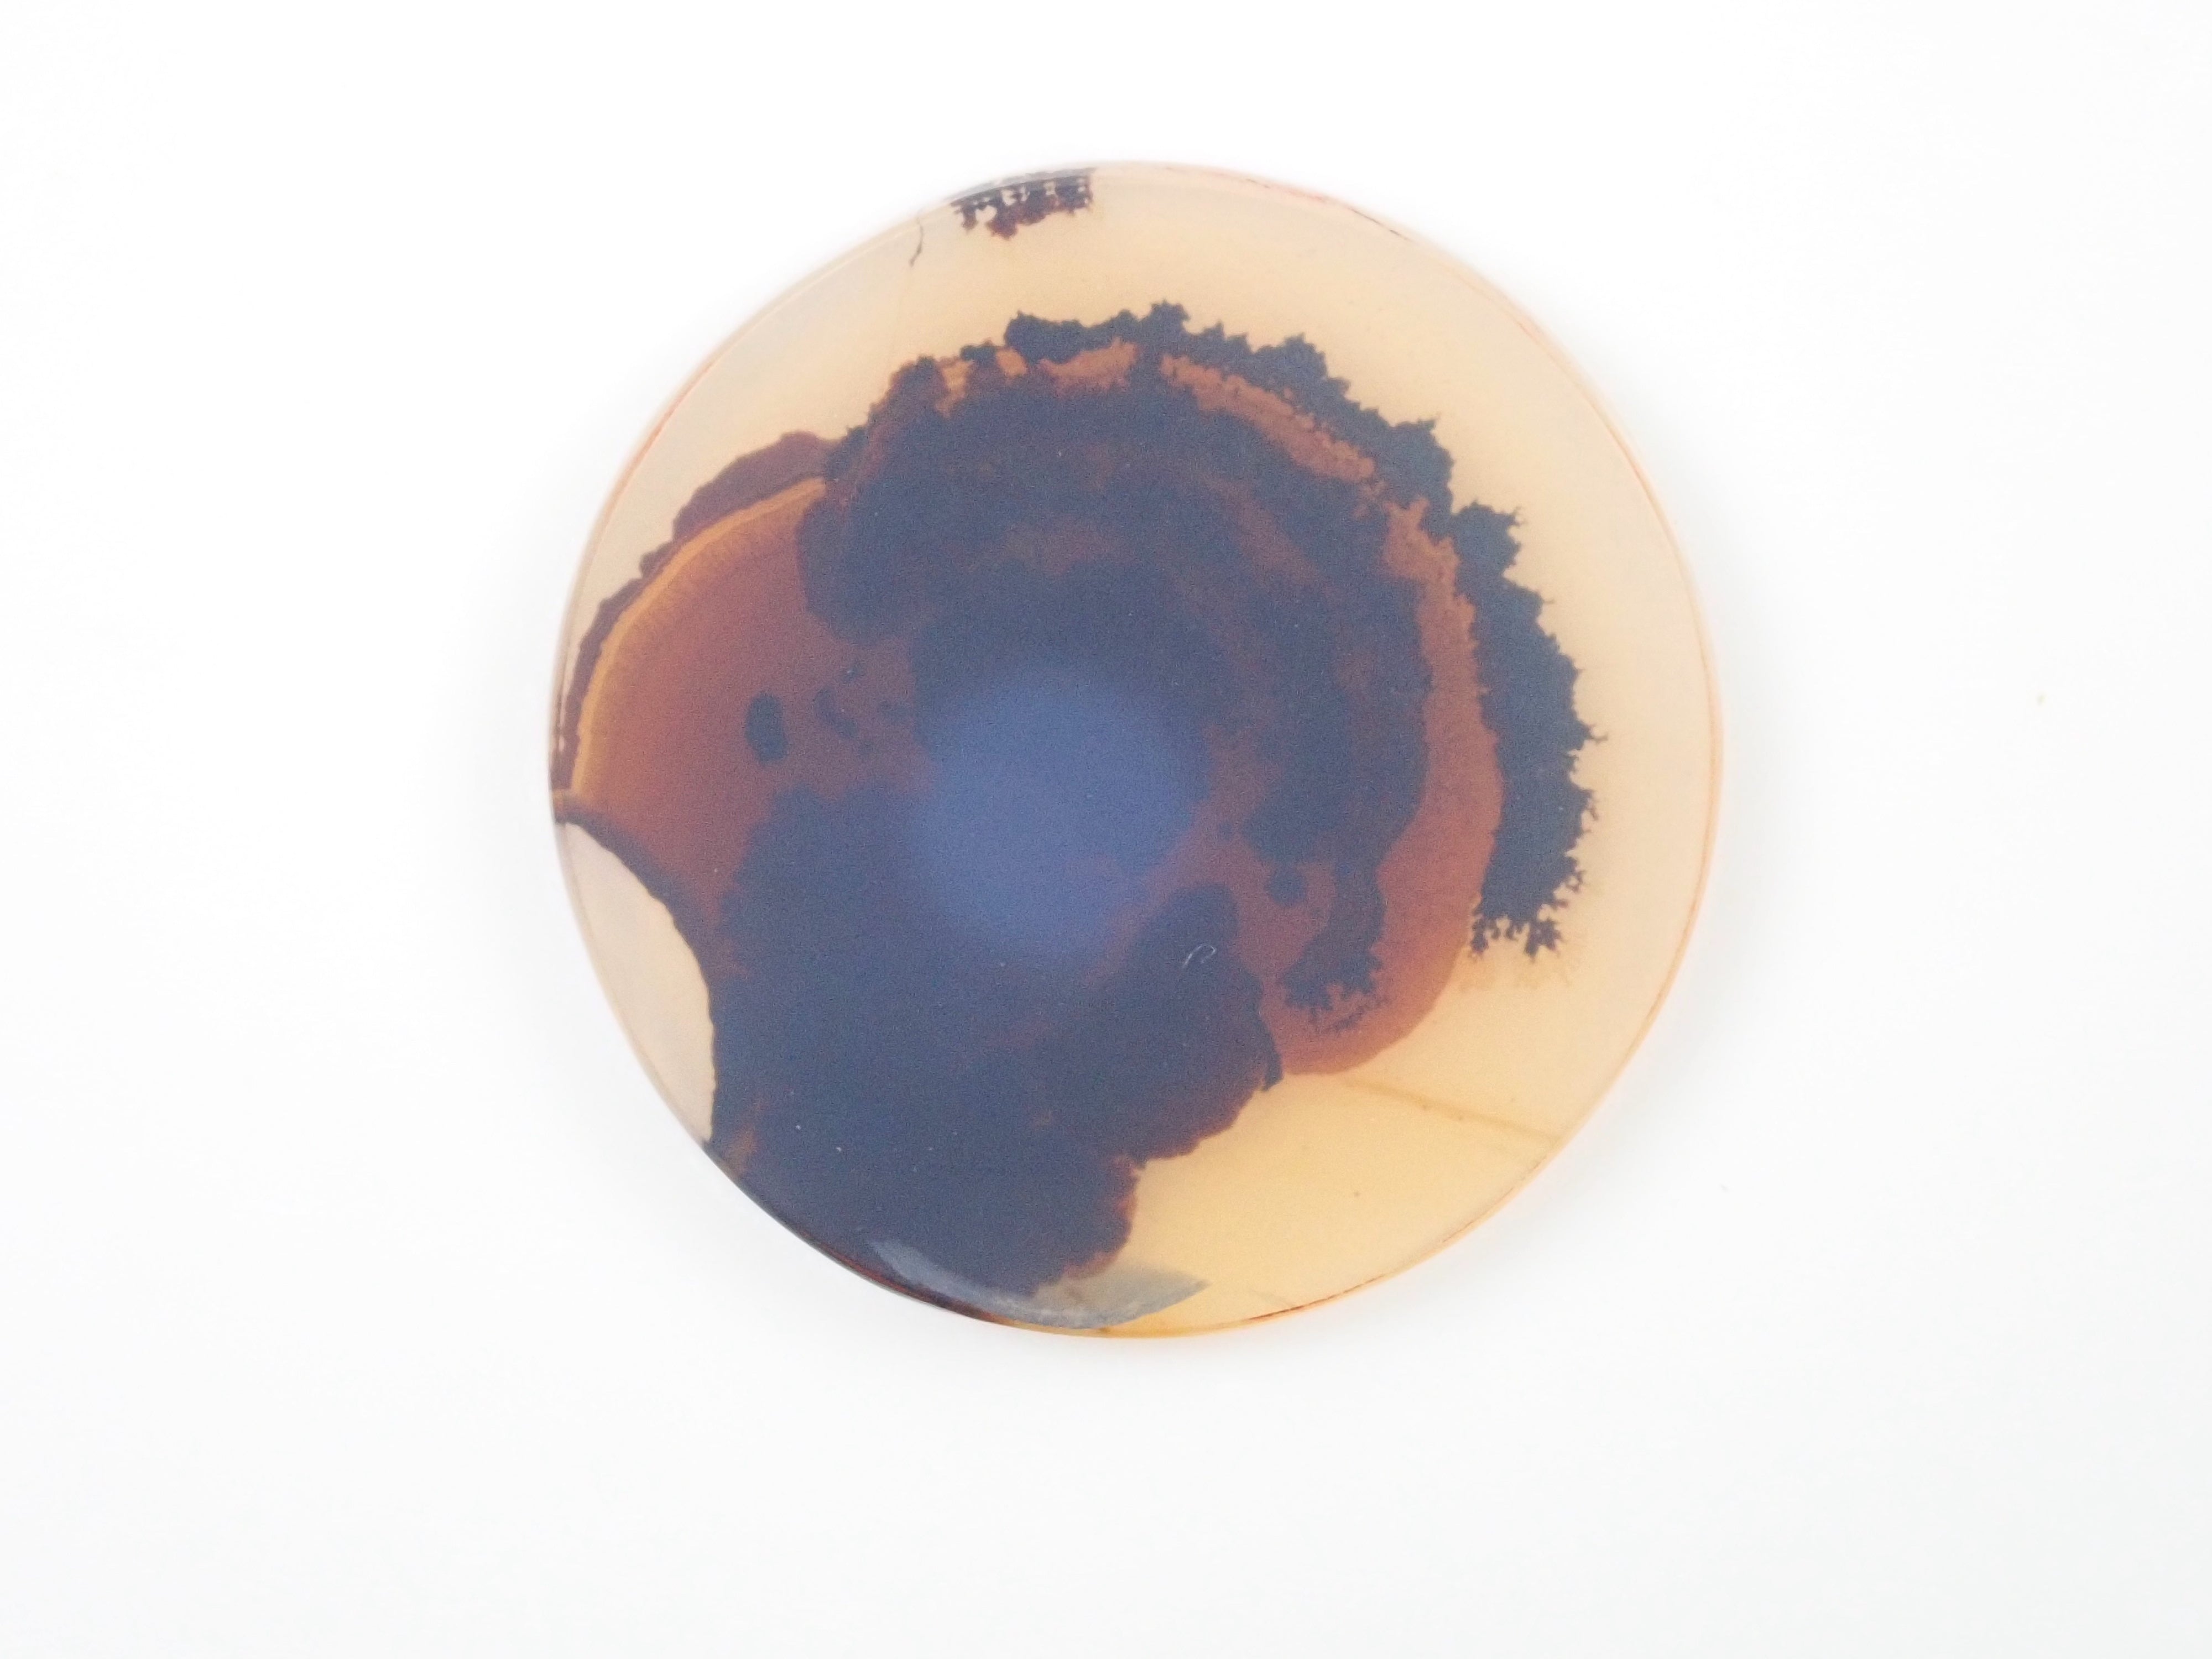

樹枝狀瑪瑙 7.179 克拉裸石
這是瑪瑙內部有樹枝狀圖案的樹枝狀瑪瑙。沒有任何寶石具有相同的圖案,這塊石頭肯定會吸引收藏家。它是如此美麗,以至於你無法相信這是自然的創造。
・類型:散裝(天然石)
・寶石名稱:樹枝狀瑪瑙
・重量:7.179ct
・刮痕/缺口:S
・包含:- ·評論: - -
・配件:Karatz 品質保證卡、盒子
▷有關樹突狀體的更多信息
樹枝狀石英的如畫世界是怎麼樣的?
*我們盡力確保照片中的顏色與實物相同,但根據拍攝時的光線和您使用的顯示器環境,顏色可能與實物略有不同。此外,有些照片可能是使用筆燈拍攝的。
*按此處了解有關刮痕、缺口、處理和內含物的資訊。
*其他常見問題,請點擊此處。
karatz_item_id:12543183
・類型:散裝(天然石)
・寶石名稱:樹枝狀瑪瑙
・重量:7.179ct
・刮痕/缺口:S
・包含:- ·評論: - -
・配件:Karatz 品質保證卡、盒子
▷有關樹突狀體的更多信息
樹枝狀石英的如畫世界是怎麼樣的?
*我們盡力確保照片中的顏色與實物相同,但根據拍攝時的光線和您使用的顯示器環境,顏色可能與實物略有不同。此外,有些照片可能是使用筆燈拍攝的。
*按此處了解有關刮痕、缺口、處理和內含物的資訊。
*其他常見問題,請點擊此處。
karatz_item_id:12543183
選擇選項

樹枝狀瑪瑙 7.179 克拉裸石
促銷價¥9,800
原價